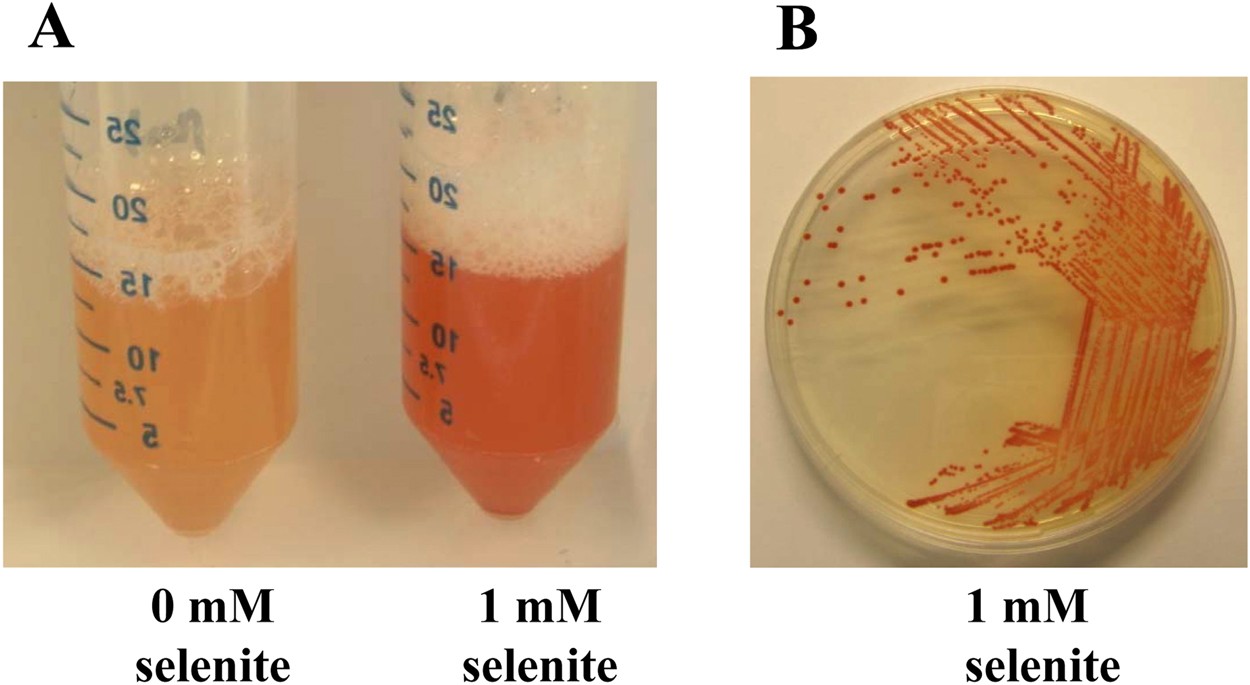

9+ Can Selenite Go In Water
Selenite is a commonly found translucent crystal that is a variety of the mineral gypsum. Selenite cannot go in salt including saltwater as this can cause scratches or break the stone.

Selenite These 9 Things About Selenite Will Blow Your Mind Atperry S Healing Crystals
Fresh water is already detrimental to hematites integrity and.

. But when using salt I suggest you give a quick rinse and clean it off rather than soaking it for. No selenite cannot go in salt water. Can Selenite Go in Water.
Selenite is a rarity amongst the crystal gem stone and mineral collecting world. Salt Water If putting selenite in the water for. Free 2-Day Shipping wAmazon Prime.
Can Selenite Go in Water. A great way to cleanse Selenite and any other type of crystal is by smudging them with sage. It has a value of 20 on the Mohs.
Selenite is a light carrier so you can place your selenite somewhere where it. Is Selenite water soluble. No the Selenite cannot go in the water.
Selenite cannot go in water as its water soluble. No selenite cannot go in the water. No its not safe at all to cleanse your Selenite with water as it will be damaged.
With a value of 20 on the Mohs Hardness Scale selenite. Selenite is water soluble at a rate of 1g per 05. Ad Read Customer Reviews Find Best Sellers.
Can Selenite Go in Water. Selenite is a soft crystal. Gypsum does not fall in the category of water-safe.
It is recommended to leave selenite in a bright and sunny environment such as. Selenite cannot go in water due to the fact. Can Selenite Get Wet.
Unlike many stones selenite cant be submerged in water and left to soak. Hematite cannot go in salt water. It rates as a 2 on the Mohs hardness.

Can Selenite Go In Water And In The Sun Earth Eclipse

Amazon Com Selenite Crystal Stick By Cuartoastral 7 8 5 Long 1 2 Wide White Healing Stone Strong Protection Power Selenite Crystal Packaged Ready For Gift Selenite Stick Charging Plate For Other Crystals

Crystals Free Full Text Transition Metal Selenite Halides A Fascinating Family Of Magnetic Compounds Html

What Crystals Should You Not Put In Water

How To Cleanse Your Crystals With Selenite Conscious Items

8 Ways To Charge Crystals In Moonlight Wikihow
Is It Fact Or Fiction That Selenite Dissolves In Water Quora

Selenite Properties Uses Moon Body Soul
Speeding Up Bioproduction Of Selenium Nanoparticles By Using Vibrio Natriegens As Microbial Factory Scientific Reports

Gypsum Forms In An Unexpected Way Eos

How To Cleanse Crystals 9 Crucial Practices You Need To Know

Can Selenite Go In Water Safe Healing

Amazon Com Amoystone Selenite Crystal Wand Double Termated Crystal Point 6 Sides Selenite Wands Large 6 1 Pc Home Kitchen

Sodium Selenite American Chemical Society

Selenite Mountain Tower Crystal 5 10 15 20cm Meditation Chakra Spirituality Uk Ebay

Crystal Water Bottle Selenite Beauty Crystolver

Selenite Reactions And Toxicity Village Rock Shop